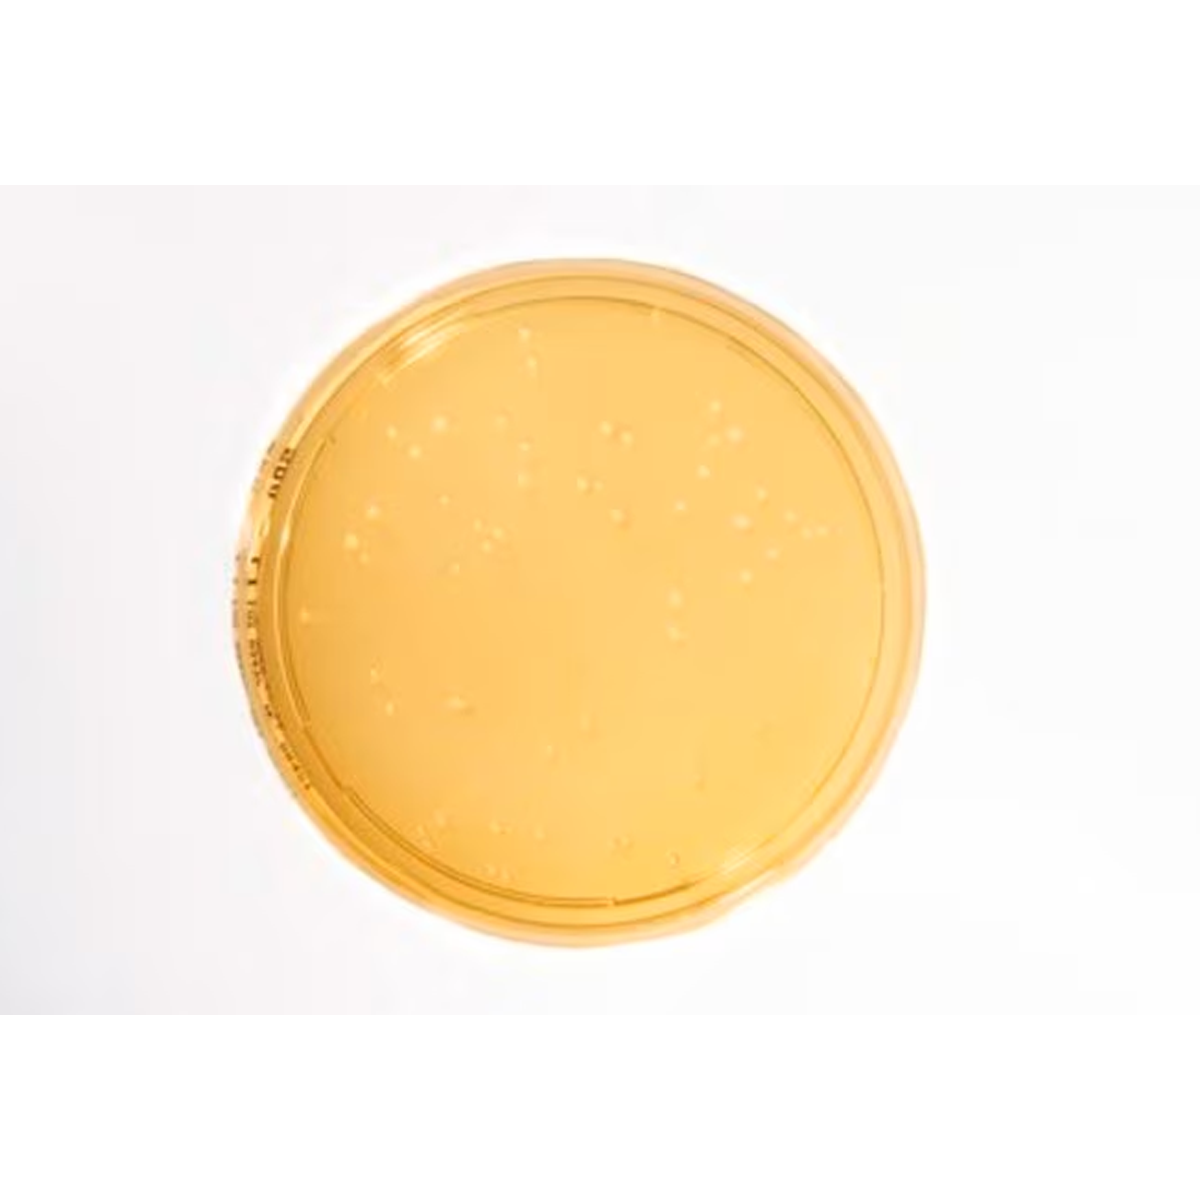

1
/
of
1
SKU:1460280020
Merck
Sabouraud Dextrose Agar
Sabouraud Dextrose Agar
Temporarily out of stock or special order item. Our customer service will provide a delivery estimate.
Product description
Product description
Heimplate, EP, JP, USP, Settle plate for long incubation, plate diam. 90 mm, sterile, single packed of 20 or 120 plates, suitable for air monitoring
Additional information
Additional information